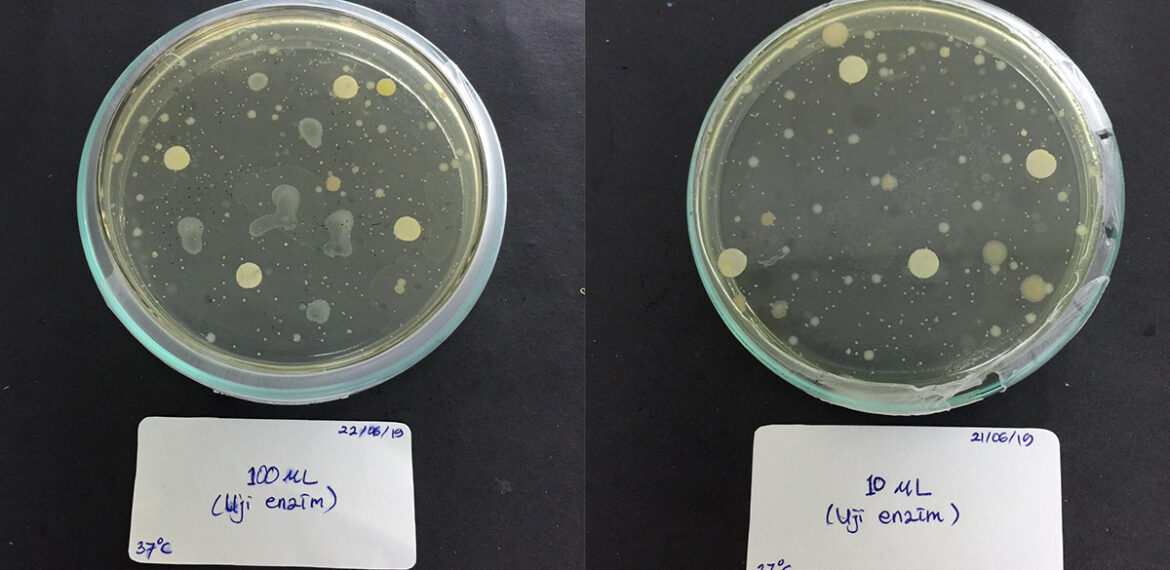
tumbuhkan-bakteri-pengurai-plastik-mahasiswa-ipb-university-manfaatkan-labu-news

Cultivates Plastic-degrading Bacteria, IPB University Students Utilize Pumpkin
The issue about plastic pollution keeps on undergoing improvement each year attains big attention from researchers. Plastic can be degraded with the help of microorganisms such as bacteria. However, plastic-degrading bacteria is not easy to get because they need special media according to their needs.
Because of that, IPB University students, Water Resource Management Department, Inka Destiana Sapitri, Ega Hana Masitoh and Ghinarrahmi Afiyatillah conducted a research to cultivate plastic-degrading bacteria Pseudomonas aeruginosa in summer squash seed-based media.
Inka explains that summer squash seed utilization is still lacking in Indonesia. “The amino acid content in summer squash seed has many benefits. The arginine, alanine, and isoleusin in summer squash seed can increase the growth rate of Pseudomonas aeruginosa,” she said.
With this idea, the team advised by Inna Puspa Ayu, SPi, MSi managed to acquire the funding from Ministry of Research, Technology, and Higher Education (Kemenristekdikti) in Student Creativity Program in Research (PKMPE) 2019.
This team extracts summer squash seeds using the protein separation principal. Moreover, the extract is made as a material for plastic-degrading bacteria growth media. The team also conducts proximate test and amino acid content test using High Performance Liquid Chromatography (HPLC). From the research result, Inka explains that the time and application of summer squash seed extract influence the growth of Pseudomonas aeruginosa sp’s growth.
The result of the test can be seen quite clearly. The growth of Pseudomonas aeruginosa with summer squash seed (Curcubita moschata) treatment is faster than the control bacteria culture,” she said.
The difference in growth rates is because the difference of nutrition between two media. The media with summer squash seed extract has arginine, alanine, and isoleusin amino acids. The amino acid content has the role in the growth. This shows that summer squash seed extract can be an additional supplement to improve Pseudomonas aeruginosa’s growth rate.
“Pseudomonas aeruginosa, according to several preceding studies are presumed to produce lipolytic enzyme that can degrade plastic,” she said. She added that a follow-up study is needed to prove the effect of summer squash seed extract to plastic degradation and its application in our environment. (Ard)


